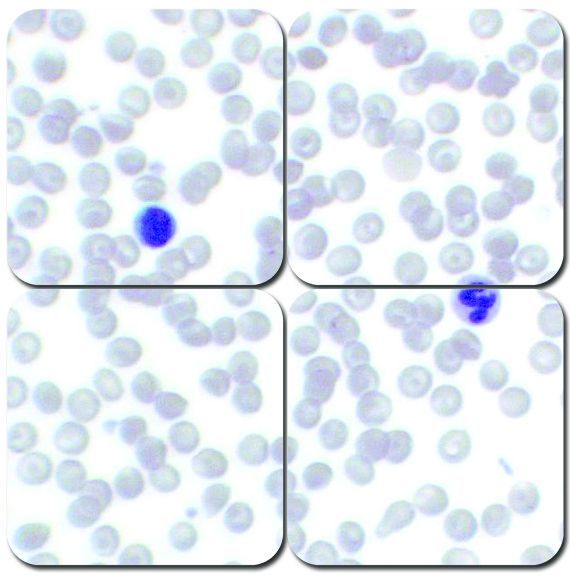

Products
We offer an extensive product line in Anatomical Pathology
Pathcare has a complete line of pathology consumable products including customized products. We will also source unique products for our customers.
Our website includes our most popular products and in addition we carry all types of microscope slides, coverglass, coverfilm, slide and cassette Storage, paraffin, mounting medium, Xylene and Alcohol and other reagents, all Formalin products and other fixatives, prefilled specimen containers, dissection instruments and scalpel blades, decalcifiers, control slides, H&E stains, labels, cytology stains, slide folders, base molds, cassettes, taped cassettes, gloves, microtome blades, consumables for biopsy and specimen transport and much more.
We also carry equipment including waterbaths, tissue floatation baths, microtomes, embedding centers, ovens, wax dispensers, fume hoods, slide drying tables, cryostats, filters, ink cartridges and refurbished equipment. We also carry Immunohistochemistry (IHC) consumables.
Call us at 1800-705-1042 or email us at sales@pathcare.ca
for more information or to help find a product.